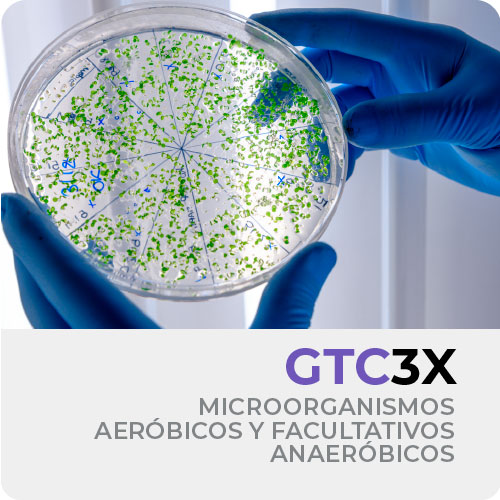

GTC 3X – Microorganismos Aeróbicos y Facultativos Anaeróbicos
Producto para tratamiento para cámaras de grasas formulado con microorganismos de ocurrencia natural altamente adaptado y alto desempeño.
DESCRIPCIÓN
Estos microorganismos son aeróbicos y facultativos anaeróbicos que pueden prosperar en múltiples condiciones dentro de las trampas de grasas, logrando así un fuerte aumento en la eficiencia del sistema, reduciendo los bloques y su consecuente emanación de malos olores.